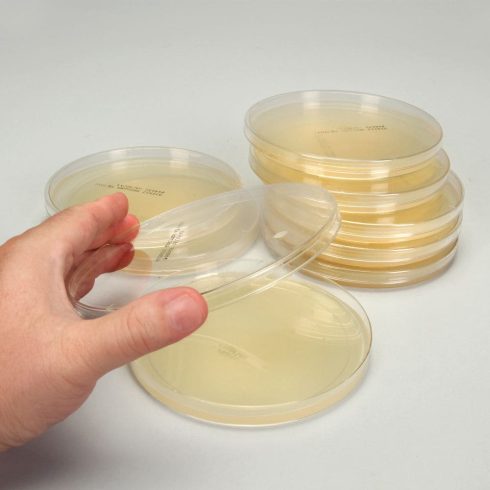
مولر هینتون آگار

ابزار و وسایل آزمایشگاهی شامل، محلول ها کیت ها
مولر هینتون آگار (MHA): ترکیب، اساس، کاربردها و آماده سازی
مقدمهای بر مولر هینتون آگار (MHA)
مولر و هینتون در سال ۱۹۴۱ مولر هینتون آگار (MHA) را برای جداسازی گونههای بیماریزای نایسریا ایجاد کردند. امروزه بیشتر برای آزمایش حساسیت معمول میکروارگانیسمهای غیر مستعد با تکنیک انتشار دیسک Kirby-Bauer استفاده میشود.
پنج درصد خون گوسفند و نیکوتین آمید آدنین دی نوکلئوتید نیز ممکن است در هنگام انجام آزمایش حساسیت روی گونههای استرپتوکوک اضافه شود. این نوع معمولاً برای تست حساسیت کمپیلوباکتر نیز استفاده میشود.
ترکیبات محیط کشت مولر هینتون آگار (MHA)
| مواد تشکیل دهنده | گرم / لیتر |
| عصاره گوشتی | 2.00 gm |
| اسید هیدرولیزات کازئین | 17.50 gm |
| نشاسته | 1.50 gm |
| آگار | 17.00 gm |
| آب مقطر | 1000 ml |
PH نهایی محیط 1± 7.3 در دمای 25 درجه سانتی گراد
اساس محیط کشت مولر هینتون آگار (MHA)
محیط کشت مولر هینتون حاوی عصاره گوشت گاو، هیدرولیز اسید کازئین، نشاسته و آگار است. عصاره گوشت گاو و هیدرولیز اسید کازئین نیتروژن، ویتامینها، کربن، اسیدهای آمینه، گوگرد و سایر مواد مغذی ضروری را تأمین میکند. نشاسته برای جذب هر متابولیت سمی تولید شده افزوده میشود. هیدرولیز نشاسته باعث تولید دکستروز میشود که به عنوان منبع انرژی عمل میکند. آگار عامل انجماد است.
استفاده از محیط مناسب برای آزمایش حساسیت میکروارگانیسمها به سولفونامیدها و تری متوپریم ضروری است. تضاد با فعالیت سولفونامید توسط پاراآمینو بنزوئیک اسید (PABA) و آنالوگهای آن مشاهده شده است. کاهش فعالیت تری متوپریم، که منجر به ایجاد نواحی مهاری کوچکتر میشود، در محیط نامناسب مولر هینتون دارای سطوح بالایی از تیمیدین است.
محتوای PABA وهم چنین تیمین/تیمیدین در مولر هینتون آگار به حداقل میرسد، بنابراین غیرفعال شدن سولفونامیدها و تری متوپریم به طور قابل توجهی در هنگام استفاده از محیط برای آزمایش حساسیت ایزولههای باکتری به این ضد میکروبها کاهش مییابد.
موارد استفاده از محیط کشت مولر هینتون آگار (MHA)
- کاربرد عمده مولر هینتون آگار برای آزمایش حساسیت ضد میکروبی است. این ترکیب به یک محیط کشت استاندار برای روش بائر کربی تبدیل شده است و عملکرد آن توسط NCCLS تعیین شده است.
- میتوان از آن برای کشت نایسریا استفاده کرد
- در کتابچه راهنمای تحلیلی باکتریولوژی FDA برای آزمایش مواد غذایی و روشهایی که معمولاً روی باکتریهای هوازی و بی هوازی اختیاری انجام میشود، تعیین شده است.
چرا MHA برای تست حساسیت آنتی بیوتیکی استفاده میشود؟

- MHA یک محیط کشت غیر انتخابی و غیر متمایز است. این بدان معنی است که تقریباً همه موجودات زنده در این محیط رشد خواهند کرد.
- حاوی نشاسته است. نشاسته سموم آزاد شده از باکتریها را جذب میکند، بهطوریکه نمیتوانند با آنتیبیوتیکها تداخل داشته باشند. همچنین منجر به سرعت دادن انتشار آنتی بیوتیکها از طریق آگار میشود.
- MHA یک آگار سست است. این امر امکان انتشار بهتر آنتی بیوتیکها را نسبت به سایر پلیتها فراهم میکند. انتشار بهتر منجر به یک منطقه مهار دقیقتر میشود.
- MHA تکرارپذیری مرحله به مرحله قابل قبولی را برای تست حساسیت نشان میدهد.
- MHA در مهارکنندههای سولفونامید، تری متوپریم و تتراسایکلین غنی نیست. یعنی غلظت مهارکنندههای تیمیدین و تیمین در MHA کم است.
- هم مقدار پاراآمینوبنزوئیک اسید (PABA) و هم محتوای تیمین/تیمیدین در مولر هینتون آگار به حداقل میرسد، بنابراین غیرفعال شدن سولفونامیدها و تری متوپریم به طور قابل توجهی در هنگام استفاده از محیط برای آزمایش حساسیت سویههای باکتریایی به این ضد میکروبها کاهش مییابد.
آماده سازی محیط کشت مولر هینتون آگار (MHA)

- ۳۸ گرم از محیط کشت را در یک لیتر آب مقطر حل کنید.
- در خلال حرارت دادن به خوبی هم بزنید و به مدت یک دقیقه بجوشانید تا محیط کاملاً حل شود.
- در دمای ۱۲۱ درجه سانتیگراد به مدت ۱۵ دقیقه اتوکلاو کنید. سپس صبر کنید تا در حد دمای اتاق خنک شود.
- مولر هینتون آگار خنک شده را در پتری دیش استریل روی سطحی هموار و افقی بریزید تا عمق یکنواختی به دست آید.
- اجازه دهید تا در حد دمای اتاق خنک شود.
- Ph نهایی باید ۰٫۱ ± ۷٫۳ در ۲۵ درجه سانتیگراد باشد.
- پلیتها را در دمای ۲-۸ درجه سانتیگراد نگهداری کنید.
کنترل کیفیت محیط MHA
| کنترل مثبت | نتایج مورد انتظار |
| Escherichia coli ATCC® 25922 | رشد خوب، کلنی های زرد کم رنگ |
| Pseudomonas aeruginosa ATCC® 27853 | رشد خوب، کلنی های زرد رنگ |
| Staphylococcus aureus ATCC® 25923 | رشد خوب، کلنی های کرم رنگ |
| کنترل منفی | نتایج مورد انتظار |
| محیط تلقیح نشده | عدم تغییر در محیط |
محدودیت های محیط کشت مولر هینتون آگار (MHA)
- عوامل متعددی میتوانند بر نتایج تأثیر بگذارند: میزان تلقیح، سرعت رشد، فرمولاسیون محیط کشت و pH . برای اطمینان از نتایج قابل، رعایت دقیق پروتکلها مورد نیاز است.
- غیرفعال شدن دارو ممکن است ناشی از زمان نهفتگی طولانیمدت مورد نیاز رشد کنندگان کند باشد.
- تغییرات غلظت کاتیونهای دو ظرفیتی، عمدتاً کلسیم و منیزیم، بر نتایج آزمایش آمینوگلیکوزید، تتراسایکلین و کولیستین با سویههای aeruginosa تأثیر میگذارد.
جهت خرید و یا استعلام قیمت با ما تماس بگیرید یا در واتسپ پیام بزارید
همچنین بخوانید:
مترجم: مریم محجوب





